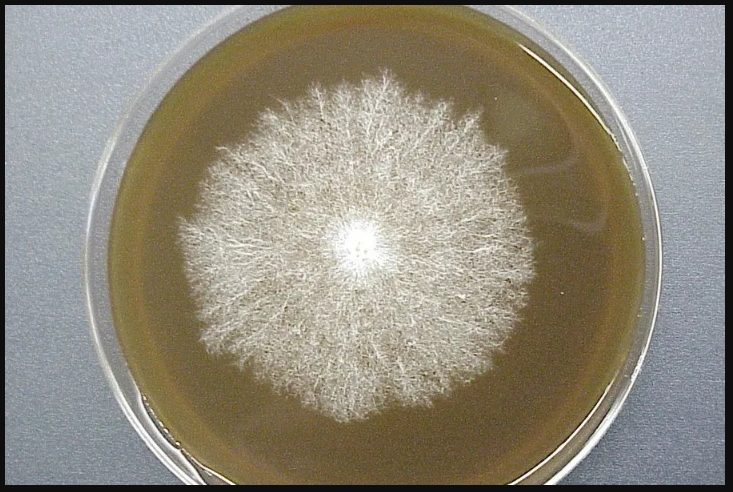
الميسيليوم (Mycelium)

لا تبحث عن “بذور” بل ابحث عن “التقاوي”
عندما يفكر أي شخص في البدء بمشروع زراعي، فإن أول ما يبحث عنه هو “البذور”. لكن في عالم زراعة الفطر (المشروم)، الأمر مختلف قليلاً. الفطر لا ينمو من بذور تقليدية مثل الطماطم أو الخيار، بل يبدأ من شيء يسمى “التقاوي” (Spawn).

اختيار التقاوي الجيدة هو حجر الأساس في مشروعك؛ فإذا كانت التقاوي ضعيفة أو ملوثة، فلن ينفعك أفضل كومبوست أو أحدث غرفة تكييف. في هذا الدليل من قسم أنا مشروم، سنشرح لك ببساطة ما هي التقاوي، وكيف تميز بين الجيد والرديء لتبدأ دورة زراعية ناجحة.
محتويات الموضوع
ما هي تقاوي المشروم (Spawn)؟
ببساطة، التقاوي هي “الوسيط” الذي نستخدمه لنقل فطر الأجاريكس (Agaricus bisporus) إلى الكومبوست الخاص بك.
تتكون التقاوي عادة من ثلاثة عناصر رئيسية:
-
الميسيليوم (Mycelium): وهو الخيوط البيضاء الدقيقة (تشبه الجذور) التي تمثل جسم الفطر الحقيقي.
-
الحامل (Grain): عادة ما تكون حبوب معقمة مثل القمح، الجاودار، أو الدخن. وظيفة هذه الحبوب هي تغذية الميسيليوم وحملة ليسهل نثره في الكومبوست.
-
بيئة معقمة: يتم تحضيرها في معامل متخصصة لضمان عدم وجود أي بكتيريا أو عفن منافس.
فكر في الأمر بهذه الطريقة: التقاوي هي “شتلات” جاهزة وقوية، تنتظر فقط وضعها في التربة (الكومبوست) لتنطلق وتنمو.
سؤال المليون: لماذا لا نزرع المشروم من “الأبواغ” (Spores) مباشرة؟
قد ترى الغبار البني الذي يخرج من أسفل قبعة المشروم الناضج، هذه هي “الأبواغ”. نظرياً، هي بذور الفطر، لكن عملياً، لا يعتمد عليها أصحاب المزارع التجارية لسببين:
-
عدم التوقع (Unpredictability): الأبواغ تشبه “الأطفال”؛ كل بوغ يحمل صفات وراثية مختلفة. إذا زرعت بالأبواغ، قد ينتج لك فطر صغير، أو بلون مختلف، أو إنتاجية ضعيفة.
-
الضعف: زراعة الأبواغ تتطلب ظروفاً معقدة جداً ونسبة نجاحها في بيئة المزرعة العادية ضئيلة.
لذلك، نستخدم التقاوي لأنها عبارة عن “استنساخ” (Clone) لسلالة قوية ومجربة. عندما تشتري تقاوي، فأنت تشتري “نسخة طبق الأصل” من فطر عالي الإنتاجية، مما يضمن لك محصولاً وفيراً ومواصفات ثابتة.
كيف تختار التقاوي الجيدة؟ (علامات الجودة)
بناءً على الخبرات العلمية والعملية، إليك القائمة الذهبية التي يجب أن تفحصها عند استلام أكياس التقاوي من المعمل أو المورد:
1. اللون والمظهر
يجب أن تكون الحبوب مغطاة بالكامل بخيوط بيضاء ناصعة (قطنية الملمس).
-
تحذير: إذا رأيت بقعاً خضراء، سوداء، أو وردية، فهذا يعني أن التقاوي ملوثة. لا تستخدمها أبداً حتى لا تدمر الكومبوست. (لمعرفة المزيد عن مشاكل التلوث التي قد تظهر لاحقاً، طالع مقالنا عن: بقع بنية أو صفراء على المشروم؟ دليلك للعلاج).
2. الرائحة (اختبار الأنف)
افتح الفلتر قليلاً وشم الرائحة. التقاوي الجيدة لها رائحة فطر قوية وطازجة.
-
تحذير: أي رائحة حموضة، تخمر، أو رائحة كريهة تعني أن التقاوي فاسدة بفعل البكتيريا (Bacterial contamination).
3. نمو “القطاعات” (Sectoring)
هذه نقطة للمحترفين. انظر للكيس، هل النمو الأبيض متجانس؟ أم أن هناك مناطق تنمو بشكل مختلف (أسرع بكثير، أو بملمس “مطاطي” وكثيف جداً في جهة واحدة)؟ هذا النمو الشاذ يسمى “Sectoring” وقد يدل على ضعف السلالة وتدهورها.
نصيحة عملية لأصحاب المزارع: هل أصنع التقاوي بنفسي؟
رغم أن فكرة صنع التقاوي في المنزل تبدو موفرة، إلا أن النصيحة العملية هي: لا تفعل ذلك في بداية مشروعك.
إنتاج التقاوي (Spawn Production) عملية تقنية للغاية تتطلب:
-
غرفة تعقيم كاملة (Lab).
-
أجهزة تعقيم بالضغط (Autoclave).
-
خبرة في عزل الأنسجة وحفظ السلالات.
أي خطأ بسيط في التعقيم سيؤدي لتلوث كل أكياس الكومبوست لديك لاحقاً. الأوفر والأضمن لك كمنتج ثمار هو شراء التقاوي من مصادر موثوقة ومعامل مرخصة، والتركيز على عملية “التحضين” و”الإثمار”.

الخلاصة
التقاوي هي استثمارك الأول. الحبة الواحدة من التقاوي هي التي ستنتشر لتملأ الكومبوست وتعطيك كيلوغرامات من الفطر. لا تبحث عن الأرخص، بل ابحث عن المصدر الذي يضمن لك “سلالة نقية” (Pure Culture) ومخزنة بشكل صحيح.

في المقالات القادمة على قسم أنا مشروم، سنشرح لك الخطوة التالية بالتفصيل: كيف تزرع هذه التقاوي داخل الكومبوست بالطريقة الصحيحة؟
الأسئلة الشائعة حول تقاوي المشروم (FAQ)
س: هل يمكنني زراعة المشروم باستخدام الحبوب العادية من السوق؟
س: كيف أقوم بتخزين التقاوي إذا لم أستخدمها فوراً؟
س: ما هي الكمية المناسبة من التقاوي للمتر المربع؟
المراجع:
-
تم الاستناد في المعلومات العلمية الواردة في هذا المقال إلى دليل جامعة ولاية بنسلفانيا (Penn State Extension) حول إدارة وزراعة فطر الأجاريكس.